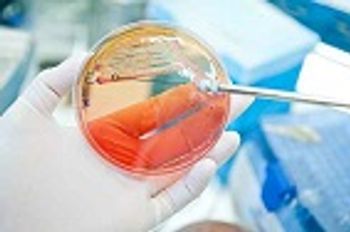

Over-the-counter diagnostic tests for Chlamydia trachomatis, Neisseria gonorrhoeae, and pathogens associated with upper respiratory tract infections such as influenza and Group A Streptococcus may soon gain approval; however, making these tests immediately available to the public would not be without challenges.